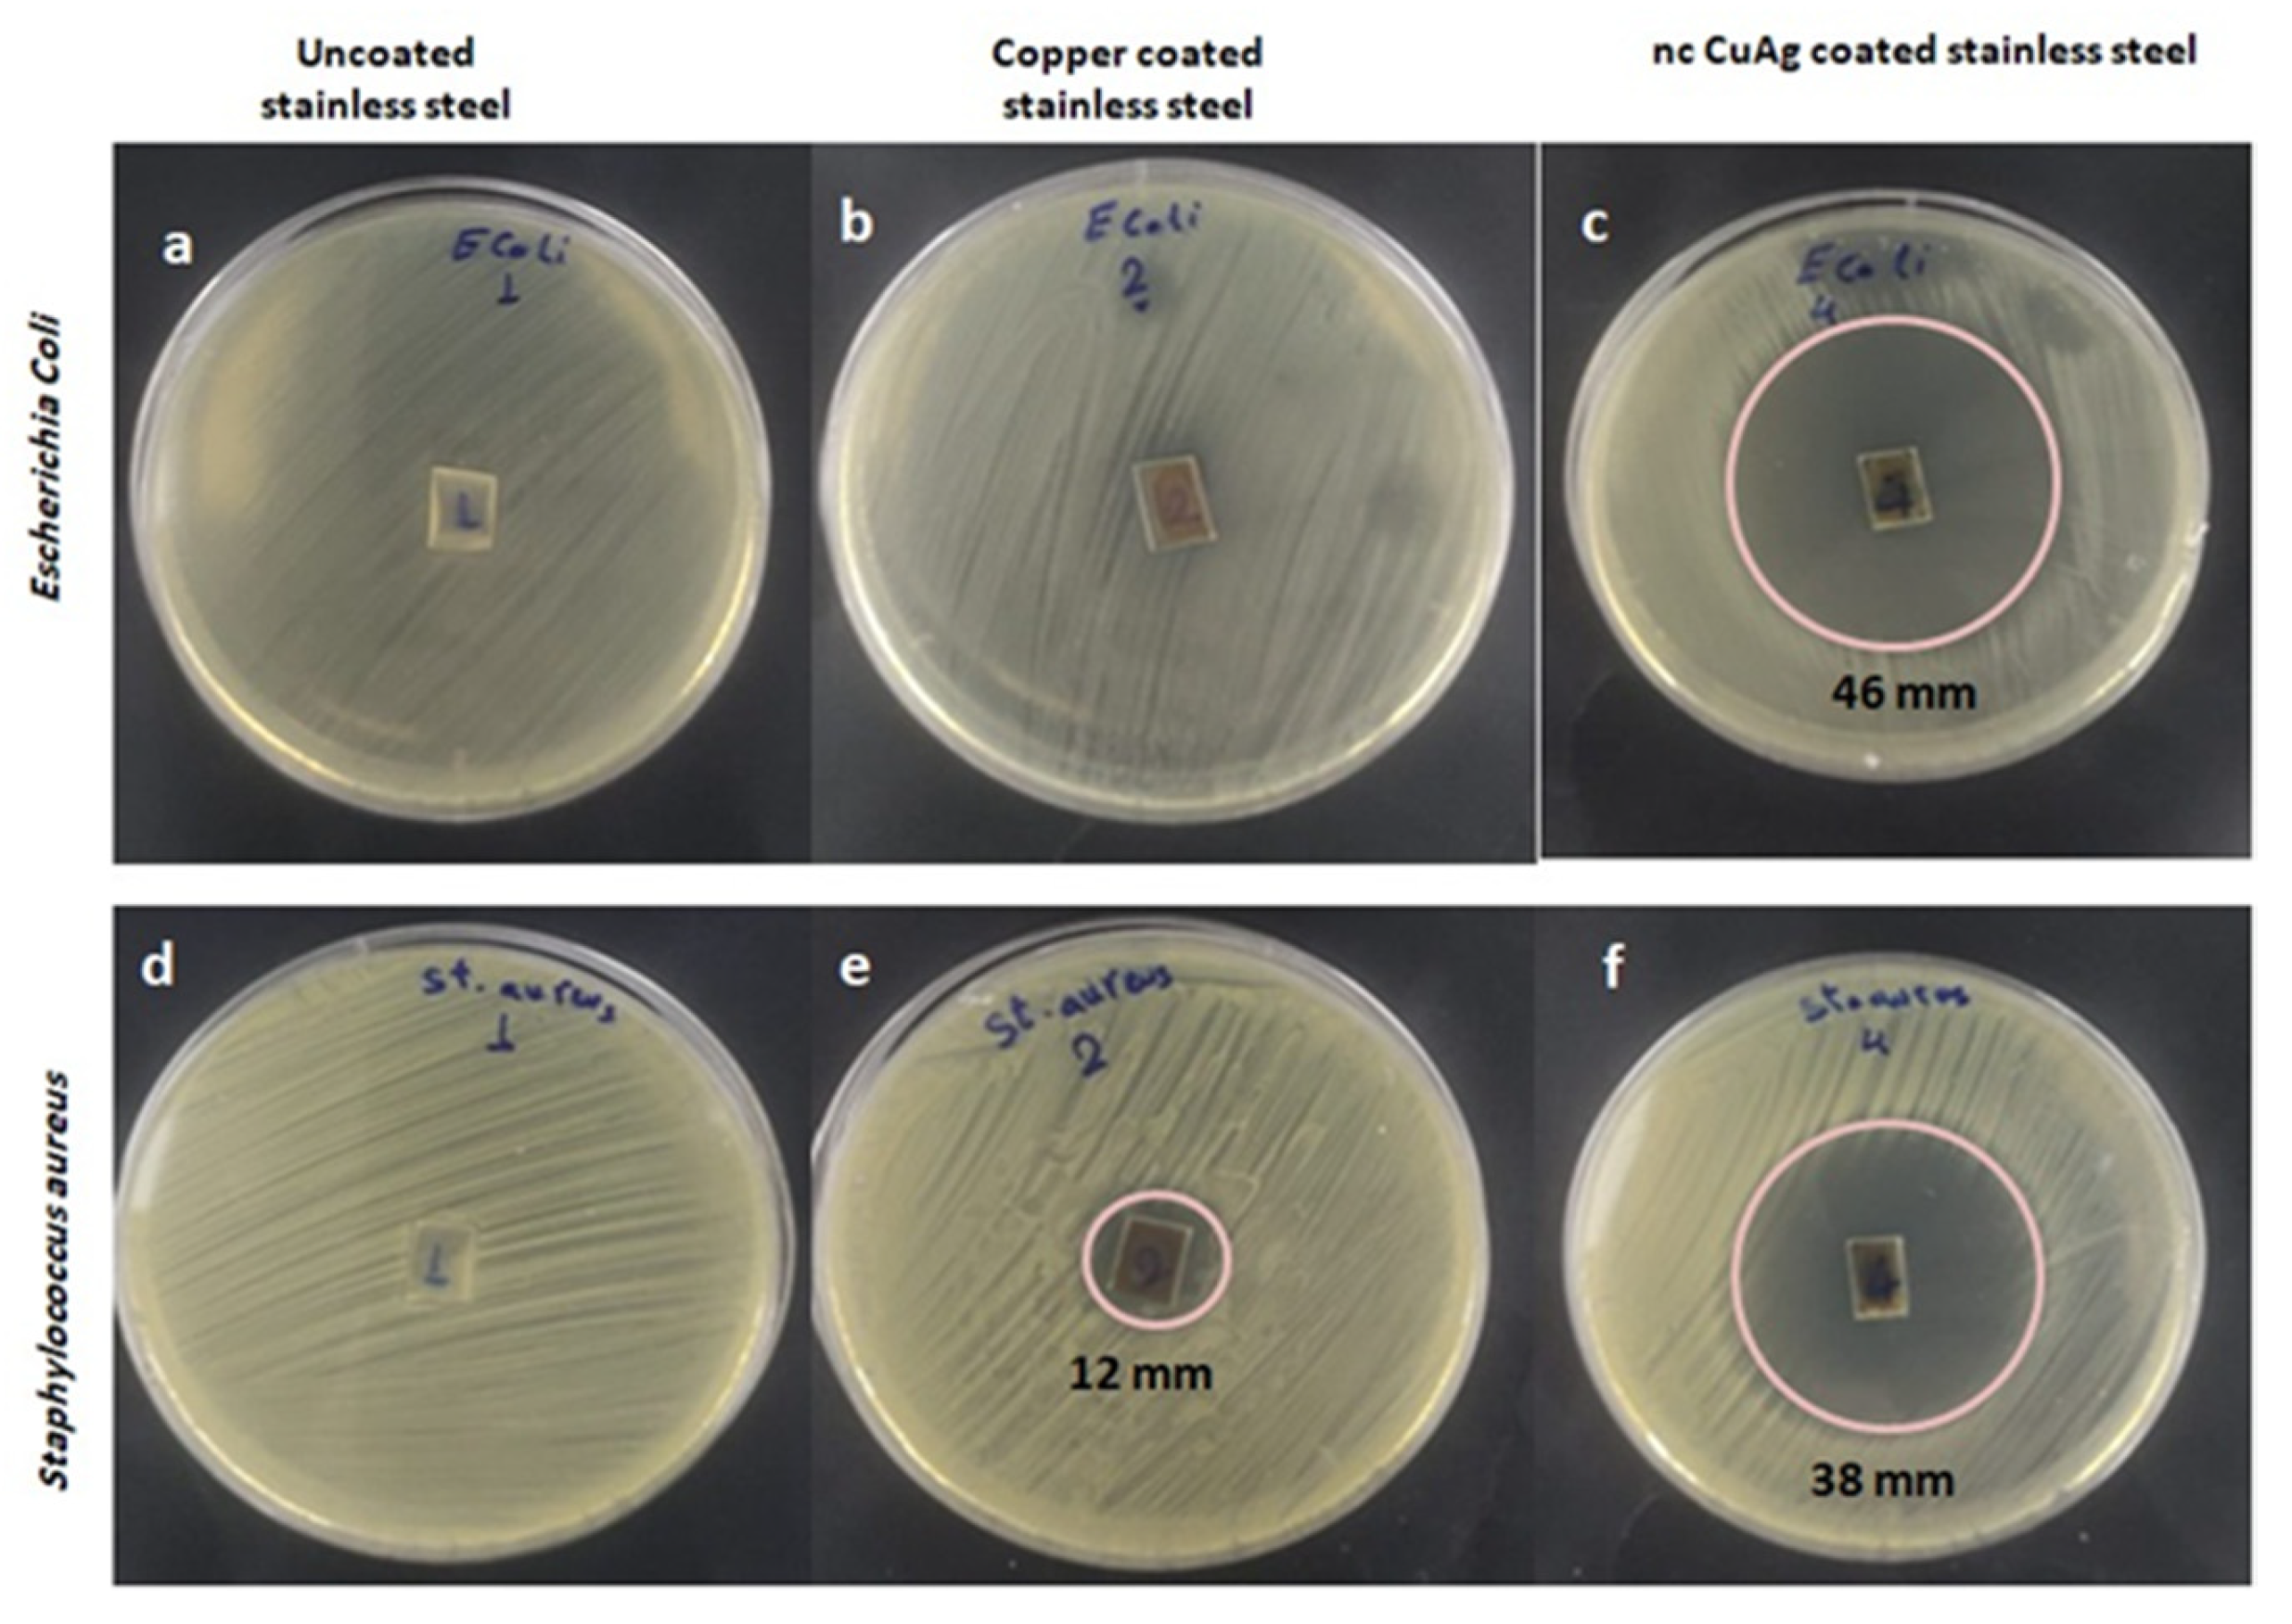

Electrochemical Synthesis of Nanocrystalline CuAg Coatings on Stainless Steel from Cyanide-Free Electrolyte
Abstract
1. Introduction
2. Experimental
2.1. Electrochemical Synthesis of ncCuAg Coatings
2.2. Antibacterial Activity Measurement
2.2.1. Organisms under Investigation
2.2.2. Assay for Agar Diffusion
3. Results and Discussion
3.1. The Electrochemical Synthesis of the ncCuAg Coating
3.2. Electrochemical Studies
3.3. Characterization of the ncCuAg
3.3.1. Surface Characterization
3.3.2. Adhesion Test of the ncCuAg Coating
3.3.3. Antibacterial Activity
4. Conclusions
Author Contributions
Funding
Data Availability Statement
Acknowledgments
Conflicts of Interest
References
- Zhang, E.; Zhao, X.; Hu, J.; Wang, R.; Fu, S.; Qin, G. Antibacterial metals and alloys for potential biomedical implants. Bioact. Mater. 2021, 6, 2569–2612. [Google Scholar] [CrossRef] [PubMed]
- Zhang, D.; Ren, L.; Zhang, Y.; Xue, N.; Yang, K.; Zhong, M. Antibacterial activity against Porphyromonas gingivalis and biological characteristics of antibacterial stainless steel. Colloids Surf. B 2013, 105, 51–57. [Google Scholar] [CrossRef] [PubMed]
- Ciacotich, N.; Kragh, K.N.; Lichtenberg, M.; Tesdorpf, J.E.; Bjarnsholt, T.; Gram, L. In situ monitoring of the antibacterial activity of a copper–silver alloy using confocal laser scanning microscopy and pH microsensors. Glob. Chall. 2019, 3, 1900044. [Google Scholar] [CrossRef] [PubMed]
- Hans, M.; Mathews, S.; Mücklich, F.; Solioz, M. Physicochemical properties of copper important for its antibacterial activity and development of a unified model. Biointerphases 2016, 11, 018902. [Google Scholar] [CrossRef]
- Medici, S.; Peana, M.; Nurchi, V.M.; Lachowicz, J.I.; Crisponi, G.; Zoroddu, M.A. Noble metals in medicine: Latest advances. Coord. Chem. Rev. 2015, 284, 329–350. [Google Scholar] [CrossRef]
- Di Cerbo, A.; Mescola, A.; Rosace, G.; Stocchi, R.; Rossi, G.; Alessandrini, A.; Preziuso, S.; Scarano, A.; Rea, S.; Loschi, A.R.; et al. Antibacterial Effect of Stainless-Steel Surfaces Treated with a Nanotechnological Coating Approved for Food Contact. Microorganisms 2021, 9, 248. [Google Scholar] [CrossRef]
- Wang, X.; Ye, X.; Zhang, L.; Shao, Y.; Zhou, X.; Lu, M.; Chu, C.; Xue, F.; Bai, J. Corrosion and antimicrobial behavior of stainless steel prepared by one-step electrodeposition of silver at the grain boundaries. Surf. Coat. Technol. 2022, 439, 128428. [Google Scholar] [CrossRef]
- Yokota, T.; Tochihara, M.; Ohto, M. Silver dispersed stainless steel with antibacterial property. Kawasaki Steel Giho. 2001, 33, 88–91. [Google Scholar]
- Sangregorio, C.; Galeotti, M.; Bardi, U.; Baglioni, P. Synthesis of Cu3Au nanocluster alloy in reverse micelles. Langmuir 1996, 12, 5800–5802. [Google Scholar] [CrossRef]
- Kim, M.J.; Na, H.J.; Lee, K.C.; Yoob, E.A.; Lee, M. Preparation and characterization of Au–Ag and Au–Cu alloy nanoparticles in chloroform. J. Mater. Chem. 2003, 13, 1789–1792. [Google Scholar] [CrossRef]
- Ang, T.P.; Chin, W.S. Dodecanethiol-protected copper/silver bimetallic nanoclusters and their surface properties. J. Phys. Chem. B. 2005, 109, 22228–22236. [Google Scholar] [CrossRef] [PubMed]
- Antipas, A.; Dolphin, D.; Gouterman, M.; Johnson, E.C. Porphyrins. 38. Redox potentials, charge transfer transitions, and emission of copper, silver, and gold complexes. J. Am. Chem. Soc. 1978, 100, 7705–7709. [Google Scholar] [CrossRef]
- Hans, M.; Támara, J.C.; Mathews, S.; Bax, B.; Hegetschweiler, A.; Kautenburger, R.; Solioz, M.; Mücklich, F. Laser cladding of stainless steel with a copper-silver alloy to generate surfaces of high antimicrobial activity. Appl. Surf. Sci. 2014, 320, 195–199. [Google Scholar] [CrossRef]
- Das, S.; Alford, T.L. Microwave assisted low temperature encapsulation of Ag films by Cu reactions using Ag–Cu alloy structures. Mater. Lett. 2012, 89, 163–165. [Google Scholar] [CrossRef]
- Rao, S.V.; Podagatlapalli, G.K.; Hamad, S. Ultrafast laser ablation in liquids for nanomaterials and applications. J. Nanosci. Nanotechnol. 2014, 14, 1364–1388. [Google Scholar] [CrossRef]
- Cai, S.; Chen, X.; Liu, P.; Zhou, H.; Fu, S.; Xu, K.; Chen, S.; Liang, D. Fabrication of three-dimensional graphene/Cu-Ag composites by in situ chemical vapor deposition and their properties. J. Mater. Eng. Perform. 2020, 29, 2248–2255. [Google Scholar] [CrossRef]
- Lei, Y.; Chen, F.; Jin, Y.; Liu, Z. Ag-Cu nano alloyed film as a high-performance cathode electrocatalytic material for zinc-air battery. Nanoscale Res. Lett. 2015, 10, 1–8. [Google Scholar] [CrossRef]
- Tan, K.S.; Cheong, K.Y. Advances of Ag, Cu, and Ag-Cu alloy nanoparticles synthesized via chemical reduction route. J. Nanopart. Res. 2013, 15, 1–29. [Google Scholar] [CrossRef]
- Tsaur, B.Y.; Lau, S.S.; Mayer, J. Continuous series of metastable Ag-Cu solid solutions formed by ion-beam mixing. Appl. Phys. Lett. 1980, 36, 823–826. [Google Scholar] [CrossRef]
- Li, D.; Liu, J.; Wang, H.; Barrow, C.J.; Yang, W. Electrochemical synthesis of fractal bimetallic Cu/Ag nanodendrites for efficient surface enhanced Raman spectroscopy. Chem. Commun. 2016, 52, 10968–10971. [Google Scholar] [CrossRef]
- Zheng, X.; Ahmad, T.; Chen, W. Challenges and strategies on Zn electrodeposition for stable Zn-ion batteries. Energy Storage Mater. 2021, 39, 365–394. [Google Scholar] [CrossRef]
- Li, K.; Chen, W. Recent progress in high-entropy alloys for catalysts: Synthesis, applications, and prospects. Materials Today Energy 2021, 20, 100638. [Google Scholar] [CrossRef]
- Wang, M.; Meng, Y.; Li, K.; Ahmad, T.; Chen, N.; Xu, Y.; Sun, J.; Chuai, M.; Zheng, X.; Yuan, Y. Toward dendrite-free and anti-corrosion Zn anodes by regulating a bismuth-based energizer. eScience 2022, 2, 509–517. [Google Scholar] [CrossRef]
- Bernasconi, R.; Hart, J.L.; Lang, A.C.; Magagnin, L.; Nobili, L.; Taheri, M.L. Structural properties of electrodeposited Cu-Ag alloys. Electrochim. Acta 2017, 251, 475–481. [Google Scholar] [CrossRef]
- Kim, M.J.; Lee, H.J.; Yong, S.H.; Kwon, O.J.; Kim, S.K.; Kim, J.J. Facile formation of Cu-Ag film by electrodeposition for the oxidation-resistive metal interconnect. J. Electrochem. Soc. 2012, 159, D253. [Google Scholar] [CrossRef]
- Yu, H.; Wang, Z.; Yang, D.; Qian, X.; Xu, Y.; Li, X.; Wang, X.; Wang, L. Bimetallic Ag3Cu porous networks for ambient electrolysis of nitrogen to ammonia. J. Mater. Chem. A 2019, 7, 12526–12531. [Google Scholar] [CrossRef]
- Shao, W.; Sun, Y.; Giurlani, W.; Innocenti, M.; Zangari, G. Estimating electrodeposition properties and processes: Cu-Ag alloy at n-Si (001) and Ru substrates from acidic sulfate bath. Electrochim. Acta 2022, 403, 139695. [Google Scholar] [CrossRef]
- Shao, W.; Sun, Y.; Xu, Y.; Zangari, G. Depolarization of Cu electrodeposition in the presence of Ag: A cyclic-voltammetry study. Electrochim. Acta 2022, 405, 139796. [Google Scholar] [CrossRef]
- De Oliveira, G.M.; Carlos, I.A. Silver–copper electrodeposition from ammonium hydroxide solution: Influence of EDTA and HEDTA. J. Appl. Electrochem. 2009, 39, 1217–1227. [Google Scholar] [CrossRef]
- Jeon, Y.; Choe, S.; Kim, H.C.; Kim, M.J.; Kim, J.J. Electrodeposition of Cu-Ag films in ammonia-based electrolyte. J. Alloys Compd. 2019, 775, 639–646. [Google Scholar] [CrossRef]
- Abdul Salam, A.; Singaravelan, R.; Vasanthi, P.; Bangarusudarsan, A.S. Electrochemical fabrication of Ag–Cu nano alloy and its characterization: An investigation. J. Nanostruct. Chem. 2015, 5, 383–392. [Google Scholar] [CrossRef]
- Chiang, C.H.; Lin, C.C.; Hu, C.C. Electrodeposition and microstructure characterization of bimetallic copper-silver films from the methanesulfonic acid baths. J. Electrochem. Soc. 2018, 165, D550–D556. [Google Scholar] [CrossRef]
- Rajagopal, V.; Velayutham, D.; Suryanarayanan, V.; Kathiresan, M.; Ho, K.C. Electrochemical fabrication of dendritic silver–copper bimetallic nanomaterials in protic ionic liquid for electrocarboxylation. J. Taiwan Inst. Chem. Eng. 2018, 87, 158–164. [Google Scholar] [CrossRef]
- Vereecken, P.M.; Binstead, R.A.; Deligianni, H.; Andricacos, P.C. The chemistry of additives in damascene copper plating. IBM J. Res. Dev. 2005, 49, 3–18. [Google Scholar] [CrossRef]
- Josell, D.; Wheeler, D.; Witt, C.; Moffat, T.P. Seedless superfill: Copper electrodeposition in trenches with ruthenium barriers. Electrochem. Solid-State Lett. 2003, 6, C143. [Google Scholar] [CrossRef]
- Reid, J. Copper electrodeposition: Principles and recent progress. Jpn. J. Appl. Phys. 2001, 40, 2650. [Google Scholar] [CrossRef]
- Lee, K.H.; Kong, W.; Han, M.; Park, D.J.; Hyuk, A.J.; Han, S.Z.; Park, Y.-B.; Choe, S. Properties of nanocrystalline CuAg foil prepared via electrodeposition. J. Alloys Compd. 2021, 881, 160522. [Google Scholar] [CrossRef]
- El Sayed, M.A.; Elazab, N.T.; Gassoumi, M.; Ibrahim, M.A.M. Nanocrystalline silver coatings on steel by electrodeposition from non-polluting aqueous baths and its antibacterial activity. J. Taiwan Inst. Chem. Eng. 2022, 132, 104212. [Google Scholar] [CrossRef]
- Zhang, J.; Sung, Y.E.; Rikvold, P.A.; Wieckowski, A. Underpotential deposition of Cu on Au (111) in sulfate-containing electrolytes: A theoretical and experimental study. J. Chem. Phys. 1996, 104, 5699–5712. [Google Scholar] [CrossRef][Green Version]
- Strehle, S.; Menzel, S.; Wendrock, H.; Acker, J.; Wetzig, K. Microstructural investigation of electrodeposited CuAg-thin films. Microelectron. Eng. 2003, 70, 506–511. [Google Scholar] [CrossRef]
- Ibrahim, M.A.M.; Bakdash, R.S. Zinc coatings of high hardness on steel by electrodeposition from glutamate complex baths. Trans. IMF 2014, 92, 218–226. [Google Scholar] [CrossRef]
- Zangari, G. Electrodeposition of alloys and compounds in the era of microelectronics and energy conversion technology. Coatings 2015, 5, 195–218. [Google Scholar] [CrossRef]
- Liang, D.; Shao, W.; Zangari, G. Selection of phase formation in electroplated Ag-Cu alloys. J. Electrochem. Soc. 2015, 163, D40–D48. [Google Scholar] [CrossRef]
- Ibrahim, M.A.M.; Bakdash, R.S. Copper-rich Cu–Zn alloy coatings prepared by electrodeposition from glutamate complex electrolyte: Morphology, structure, microhardness and electrochemical studies. Sur. Interfaces 2020, 18, 100404. [Google Scholar] [CrossRef]
- Ramakanth, K. Basic of Diffraction and Its Application; I.K. International Publishing House Pvt. Ltd.: New Delhi, India, 2007. [Google Scholar]
- Swanson, H.E.; Tatge, E. Standard X-ray diffraction patterns. J. Res. Natl. Bur. Stand. 1951, 46, 318. [Google Scholar] [CrossRef]
- Qaseem, A.; Chen, F.; Zhang, N. Ag-Cu nanoalloy electrocatalysts for oxygen reduction in alkaline media for advanced energy conversion and storage. In Advanced Catalytic Materials-Photocatalysis and Other Current Trends; InTech: West Palm Beach, FL, USA, 2016. [Google Scholar]
- Debye, P.; Scherrer, P. Interferenz an regellos orientierten Teilchen im Röntgenlicht I. Phys. Zeitschrift. 1916, 17, 277. [Google Scholar]
- Kulkarni, A.B.; Mathad, S.N. Variation in structural and mechanical properties of Cd-doped Co-Zn ferrites. Mater. Sci. Energy Technol. 2019, 2, 455–462. [Google Scholar] [CrossRef]
- Kulkarni, A.B.; Hegde, N.D.; Gowda, H.S.; Mathad, S.N. Influence of Cadmium Substitution on Structural and Mechanical Properties of Co-Ni Nano Ferrite Synthesized by Co-Precipitation Method. Macromol. Symp. 2020, 393, 1900213. [Google Scholar] [CrossRef]
- Williamson, G.K.; Hall, W.H. X-ray Line Broadening from filed aluminum and wolfram. Acta Metall. 1953, 1, 22–31. [Google Scholar] [CrossRef]
- Jin, Y.; Chen, F.; Lei, Y.; Wu, X. A Silver-Copper Alloy as an Oxygen Reduction Electrocatalyst for an Advanced Zinc-Air Battery. ChemCatChem 2015, 7, 2377–2383. [Google Scholar] [CrossRef]
- Rout, L.; Kumar, A.; Dhaka, R.S.; Dash, P. Bimetallic Ag–Cu alloy nanoparticles as a highly active catalyst for the enamination of 1,3-dicarbonyl compounds. RSC Adv. 2016, 6, 49923. [Google Scholar] [CrossRef]
- Chusuei, C.C.; Brookshier, M.A.; Goodman, D.W. Correlation of relative X-ray photoelectron spectroscopy shake-up intensity with CuO particle size. Langmuir 1999, 15, 2806–2808. [Google Scholar] [CrossRef]
- Salah, I.; Parkin, I.P.; Allan, E. Copper as an antimicrobial agent: Recent advances. RSC Adv. 2021, 11, 18179–18186. [Google Scholar] [CrossRef] [PubMed]
- Pham, A.N.; Xing, G.; Miller, C.J.; Waite, T.D. Fenton-like copper redox chemistry revisited: Hydrogen peroxide and superoxide mediation of copper-catalyzed oxidant production. J. Catal. 2013, 301, 54–64. [Google Scholar] [CrossRef]
- Ray, P.D.; Huang, B.W.; Tsuji, Y. Reactive oxygen species (ROS) homeostasis and redox regulation incellularsignaling. Cell. Signal. 2012, 24, 981–990. [Google Scholar] [CrossRef]
- Noyce, J.O.; Michels, H.; Keevil, C.W. Potential use of copper surfaces to reduce survival of epidemic meticillin-resistant Staphylococcus aureus in the healthcare environment. J. Hosp. Infect. 2016, 63, 289–297. [Google Scholar] [CrossRef]
- Ferraris, S.; Spriano, S.J.M.S. Antibacterial titanium surfaces for medical implants. Mater. Sci. Eng. C 2016, 61, 965–978. [Google Scholar] [CrossRef]
- Wang, Y.; Zhao, S.; Li, G.; Zhang, S.; Zhao, R.; Dong, A.; Zhang, R. Preparation and in vitro antibacterial properties of anodic coatings co-doped with Cu, Zn, and P on a Ti–6Al–4V alloy. Mater. Chem. Phys. 2020, 241, 122360. [Google Scholar] [CrossRef]
- Zheng, Y.F.; Zhang, B.B.; Wang, B.L.; Wang, Y.B.; Li, L.; Yang, Q.B.; Cui, L.S. Introduction of antibacterial function into biomedical TiNi shape memory alloy by the addition of element Ag. Acta Biomater. 2011, 7, 2758–2767. [Google Scholar] [CrossRef]
- Sun, D.; Xu, D.; Yang, C.; Chen, J.; Shahzad, M.B.; Sun Zhao Gu, T.; Yang, K.; Wang, G. Inhibition of Staphylococcus aureus biofilm by a copper-bearing 317L-Cu stainless steel and its corrosion resistance. Mater. Sci. Eng. C 2016, 69, 744–750. [Google Scholar] [CrossRef]
- Slawson, R.M.; Van Dyke, M.I.; Lee, H.; Trevors, J.T. Germanium and silver resistance, accumulation, and toxicity in microorganisms. Plasmid 1992, 27, 72–79. [Google Scholar] [CrossRef]
- Berger, T.J.; Spadaro, J.A.; Chapin, S.E.; Becker, R.O. Electrically generated silver ions: Quantitative effects on bacterial and mammalian cells. Antimicrob. Agents Chemother. 1976, 9, 357–358. [Google Scholar] [CrossRef] [PubMed]
- Abd-Elsalam, K.A.; Prasad, R. Nanobiotechnology Applications in Plant Protection; Springer: Berlin/Heidelberg, Germany, 2018. [Google Scholar] [CrossRef]
- Arya, G.; Sharma, N.; Mankamna, R.; Nimesh, S. Antimicrobial silver nanoparticles: Future of nanomaterials. In Microbial Nanobionics; Prasad, R., Ed.; Springer: Cham, Switzerland, 2019; pp. 89–119. [Google Scholar] [CrossRef]
- Nan, L.; Yang, K. Effect of Cu addition on antibacterial property of type 200 stainless steel. Mater. Technol. 2016, 31, 44–47. [Google Scholar] [CrossRef]

| Substance | Concentration/(M) |
|---|---|
| AgNO3 | 0.0125–0.1 |
| CuSO4 | 0.5 |
| C6H8O7 | 0.1 |
| NaOH | 0.1 |
| HNO3 | 0.05 |
| Na2SO4 | 0.14 |
| PEG | 2.0 g/L |
| Electrodeposition conditions | |
| Current density (mA cm−2) | 1.14, 1.72, 2.29, 3.43 mA cm−2 |
| Deposition time (min) | 10 min |
| Temperature (°C) | 27 |
| pH | 1.9–2.4 |
| Cathode: | Stainless steel 304 |
| Anode: | Pt sheet |
| CuAg Alloy Coatings Codeposited at 27 °C | D (nm) ± 5 |
|---|---|
| 1.14 mAcm−2, 10 min | 13.5 |
| 1.72 mA cm−2, 10 min | 16.5 |
| 2.29 mA cm−2, 10 min | 16.6 |
| 3.43 mAcm−2, 10 min | 13.9 |
| 1.72 mAcm−2, 15min | 13.4 |
| Orientation | Microstrain (ε) |
|---|---|
| (111) | 0.00442 |
| (200) | 0.00651 |
| (220) | 0.00514 |
| (311) | 0.00322 |
| (222) | 0.00351 |
| Cu pure | 0.0037 |
| Samples Prepared from Bath S under the Following Conditions | Inhibition Zone Diameter (mm) | ||
|---|---|---|---|
| Gram (+ve) Bacteria Staphylococcus aureus (ATCC 6538) | Gram (−ve) Bacteria Escherichia Coli (ATCC 8739) | ||
| Blank (uncoated SS) | NA | NA | |
| Copper only | 12 | NA | |
| CuAg alloy | (1.14 mAcm−2, 10 min) | 30 | 30 |
| (1.72 mA cm−2, 10 min) | 38 | 46 | |
| (2.29 mA cm−2, 10 min) | 29 | 33 | |
| (3.43 mAcm−2, 10 min) | 40 | 42 | |
| (1.72 mAcm−2, 15 min) | 35 | 41 | |
| (1.72 mA cm−2, 20 min) | 32 | 36 | |
| (1.72 mA cm−2, 10 min, 35 °C) | 27 | 40 | |
| (1.72 mAcm−2, 10 min, 45 °C) | 29 | 38 | |
Publisher’s Note: MDPI stays neutral with regard to jurisdictional claims in published maps and institutional affiliations. |
© 2022 by the authors. Licensee MDPI, Basel, Switzerland. This article is an open access article distributed under the terms and conditions of the Creative Commons Attribution (CC BY) license (https://creativecommons.org/licenses/by/4.0/).
Share and Cite
El Sayed, M.A.; Ibrahim, M.A.M.; T. Elazab, N.; Gassoumi, M. Electrochemical Synthesis of Nanocrystalline CuAg Coatings on Stainless Steel from Cyanide-Free Electrolyte. Processes 2022, 10, 2134. https://doi.org/10.3390/pr10102134
El Sayed MA, Ibrahim MAM, T. Elazab N, Gassoumi M. Electrochemical Synthesis of Nanocrystalline CuAg Coatings on Stainless Steel from Cyanide-Free Electrolyte. Processes. 2022; 10(10):2134. https://doi.org/10.3390/pr10102134
Chicago/Turabian StyleEl Sayed, Manal A., Magdy A. M. Ibrahim, Nahla T. Elazab, and Malek Gassoumi. 2022. "Electrochemical Synthesis of Nanocrystalline CuAg Coatings on Stainless Steel from Cyanide-Free Electrolyte" Processes 10, no. 10: 2134. https://doi.org/10.3390/pr10102134
APA StyleEl Sayed, M. A., Ibrahim, M. A. M., T. Elazab, N., & Gassoumi, M. (2022). Electrochemical Synthesis of Nanocrystalline CuAg Coatings on Stainless Steel from Cyanide-Free Electrolyte. Processes, 10(10), 2134. https://doi.org/10.3390/pr10102134
